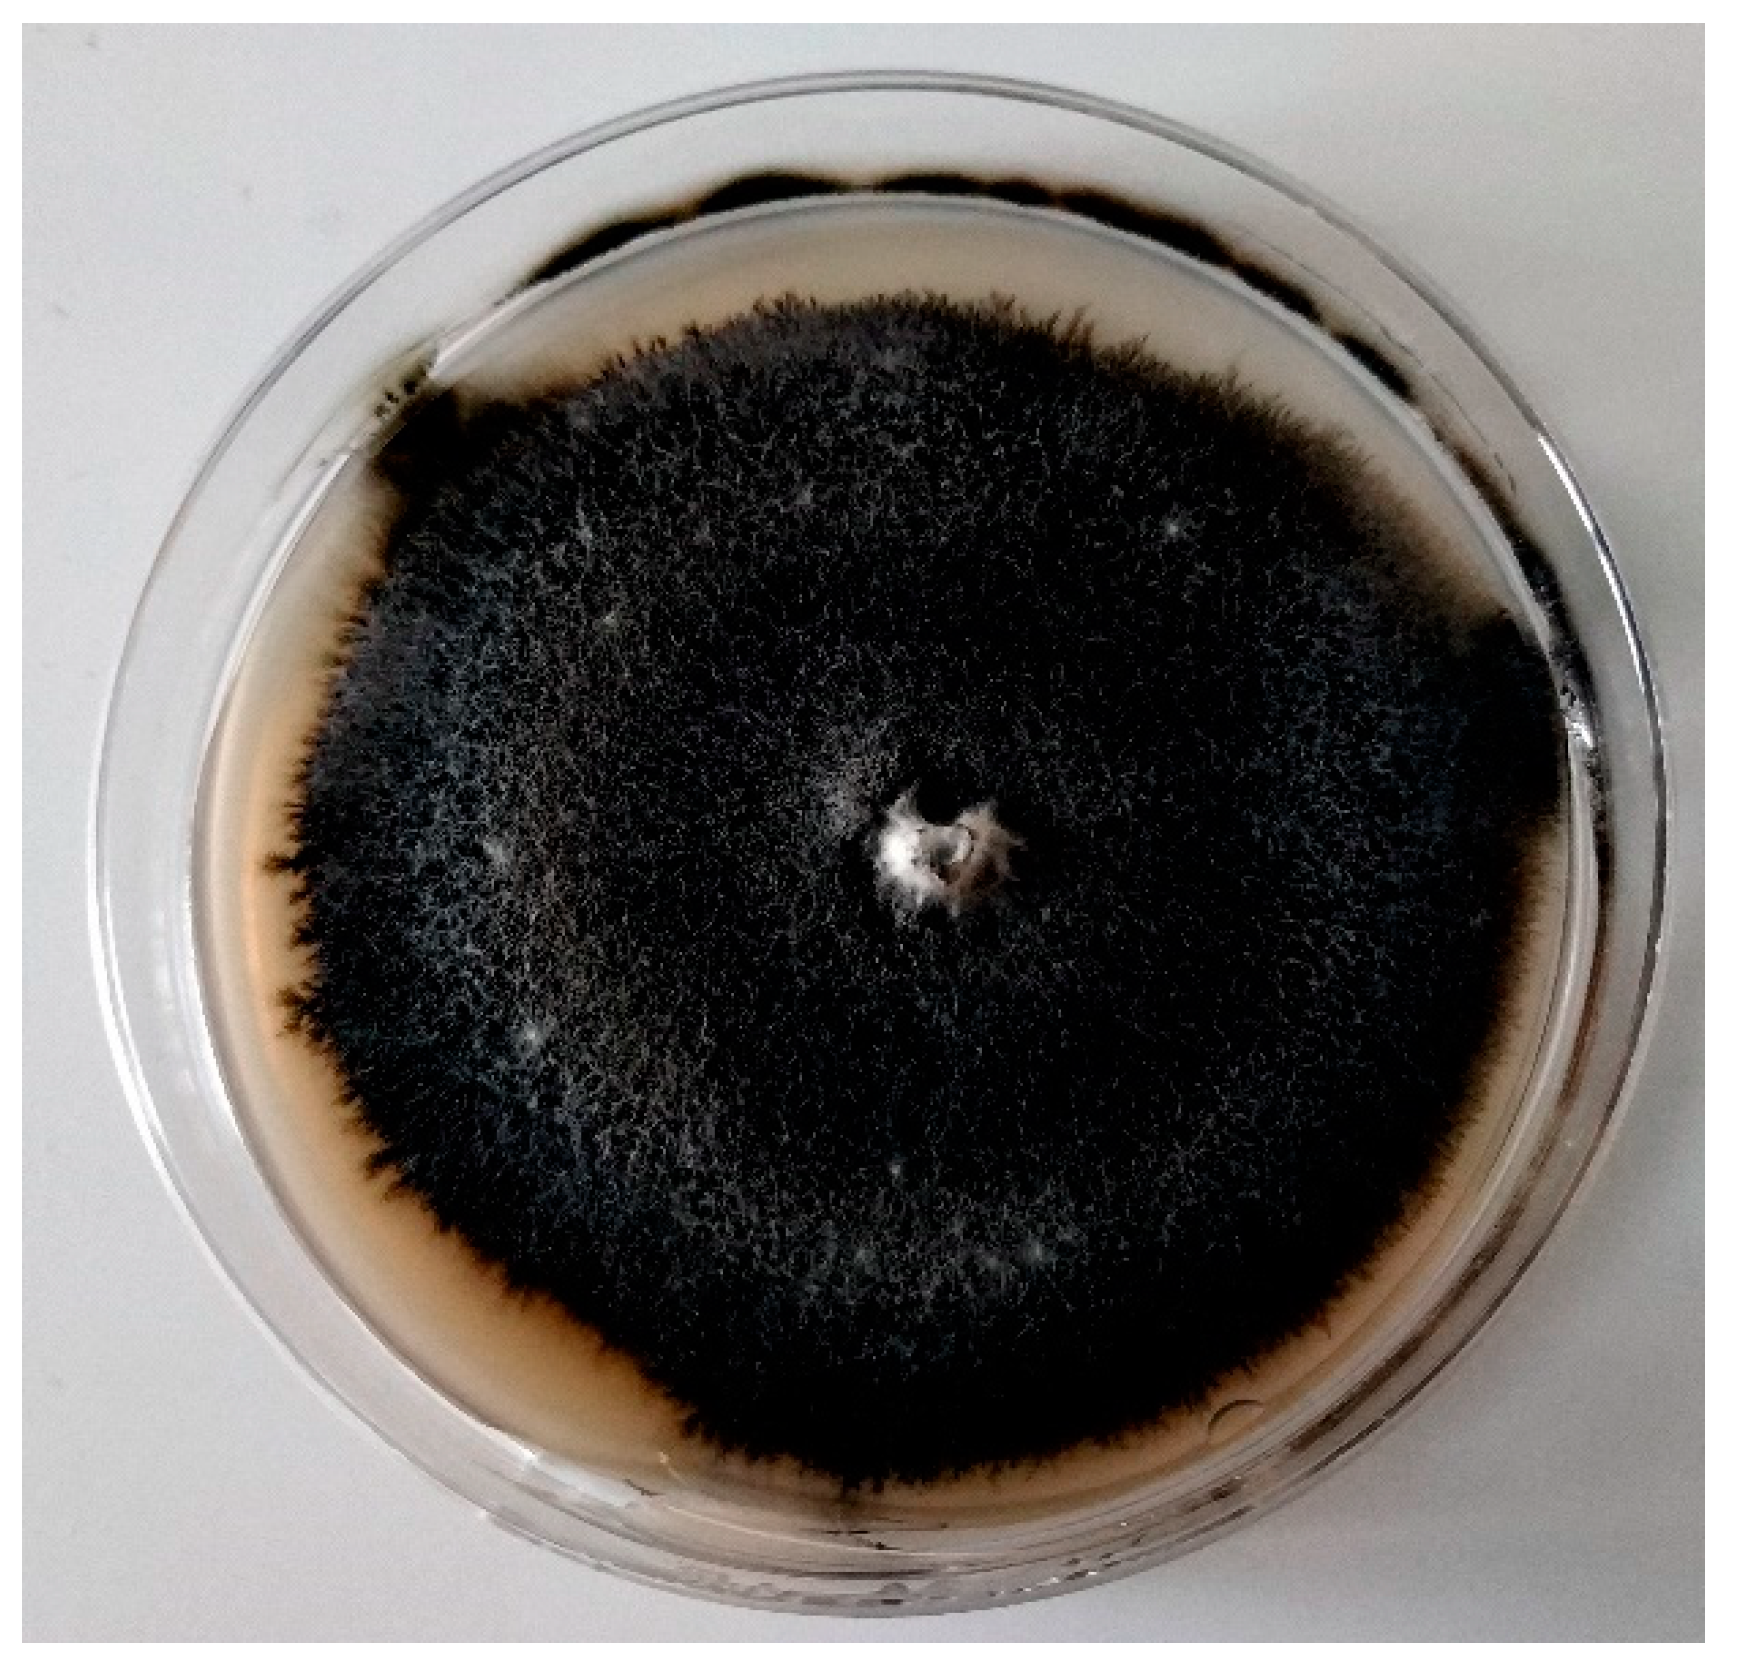
Molecules 24 01200 g001 Molecules 24 01200 g001
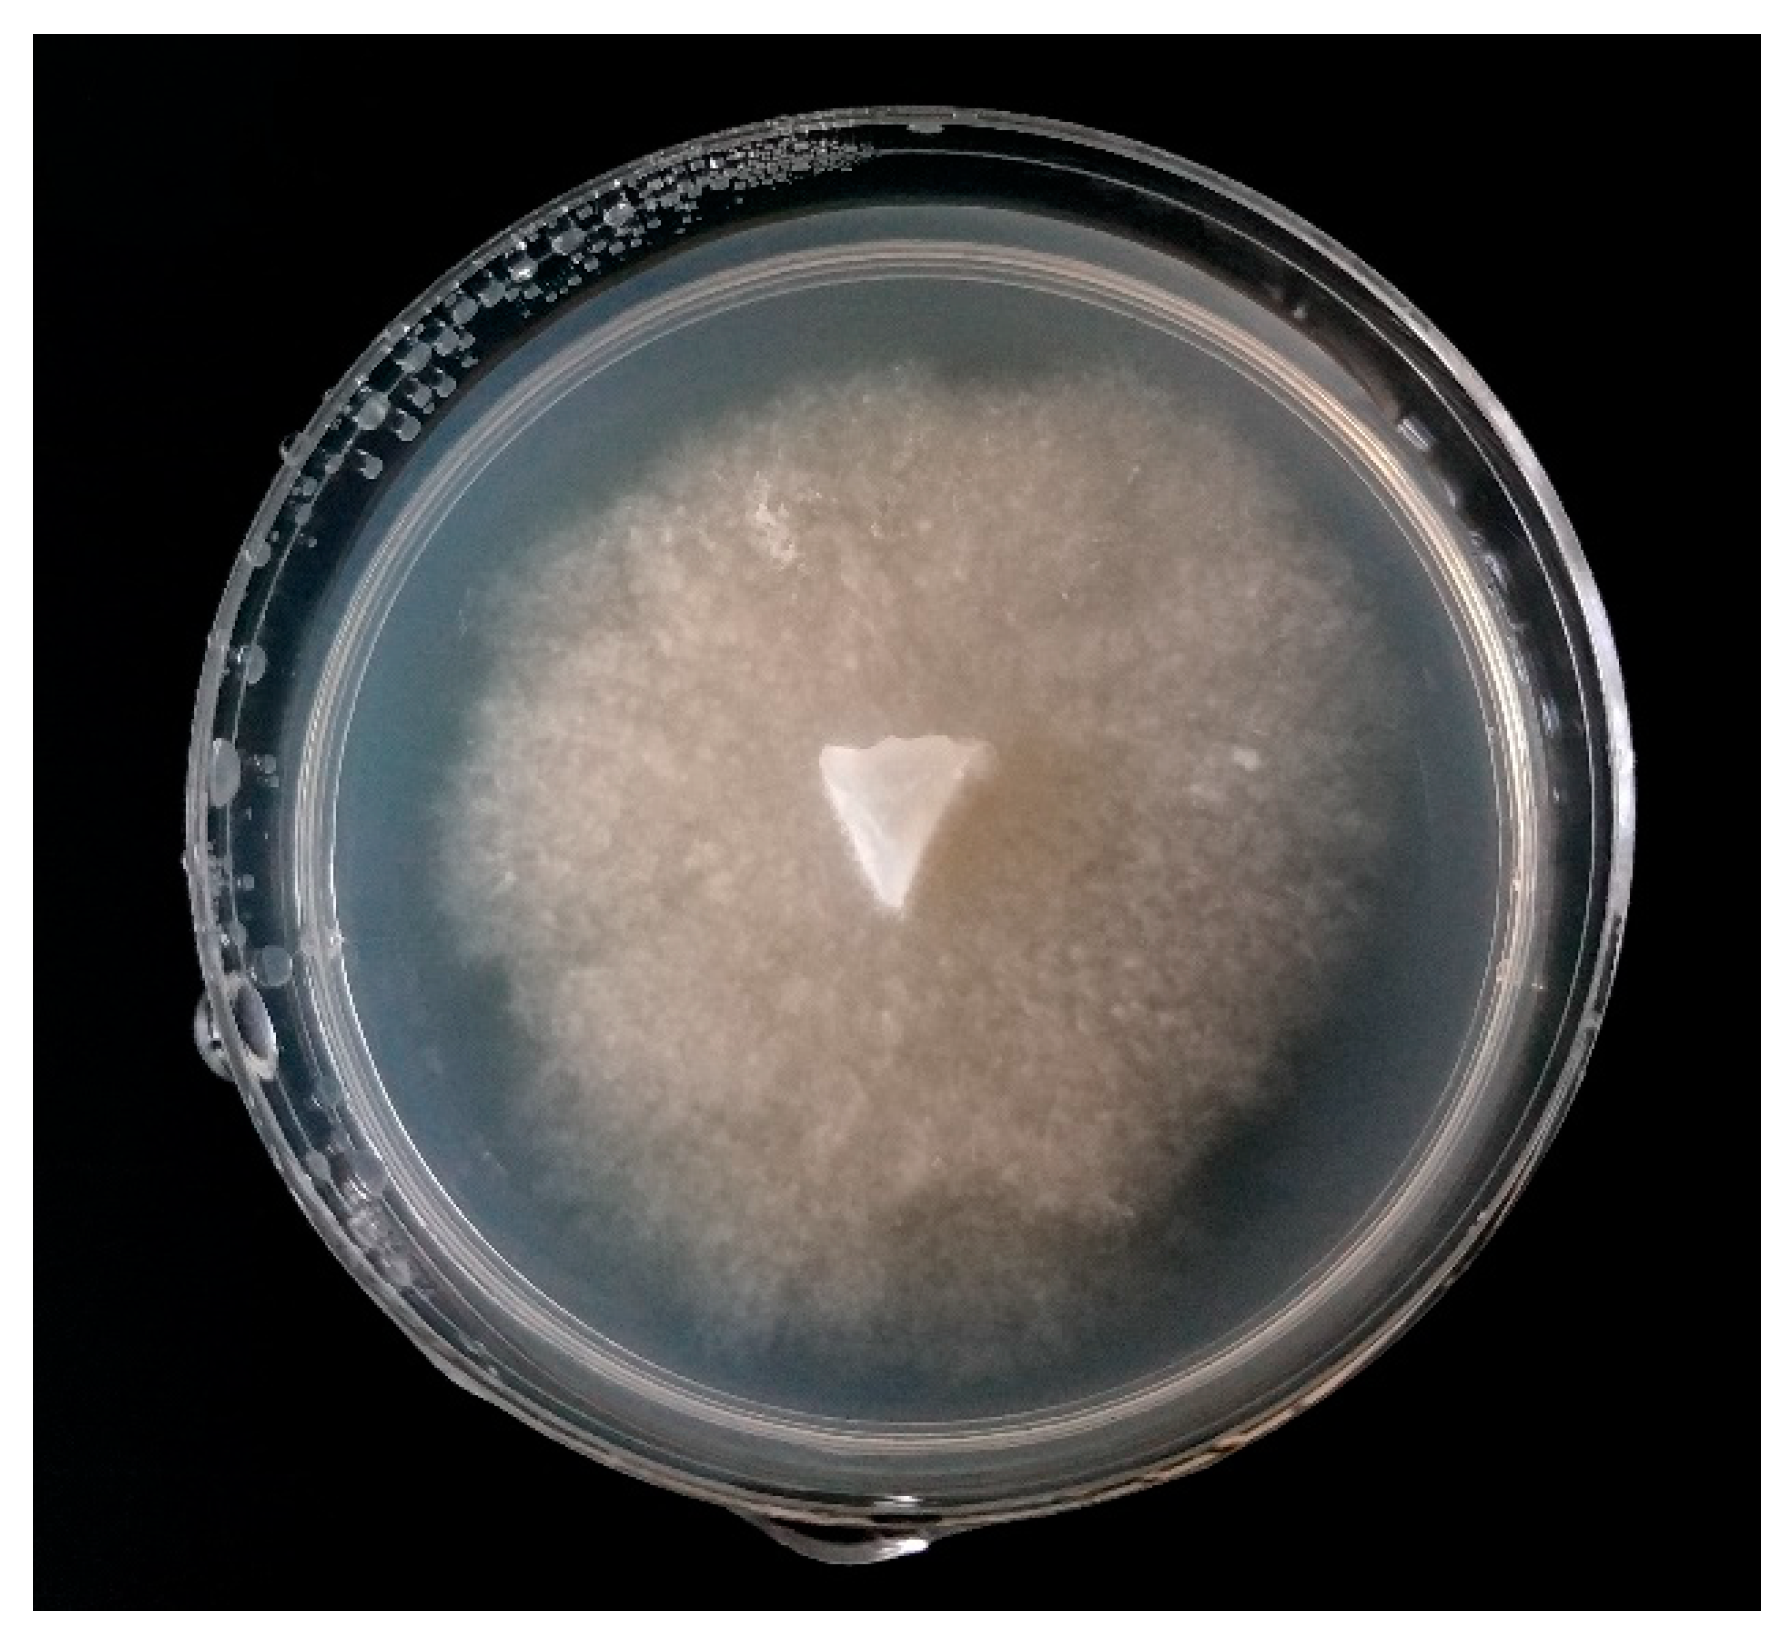
Molecules 24 01200 g002 Molecules 24 01200 g002
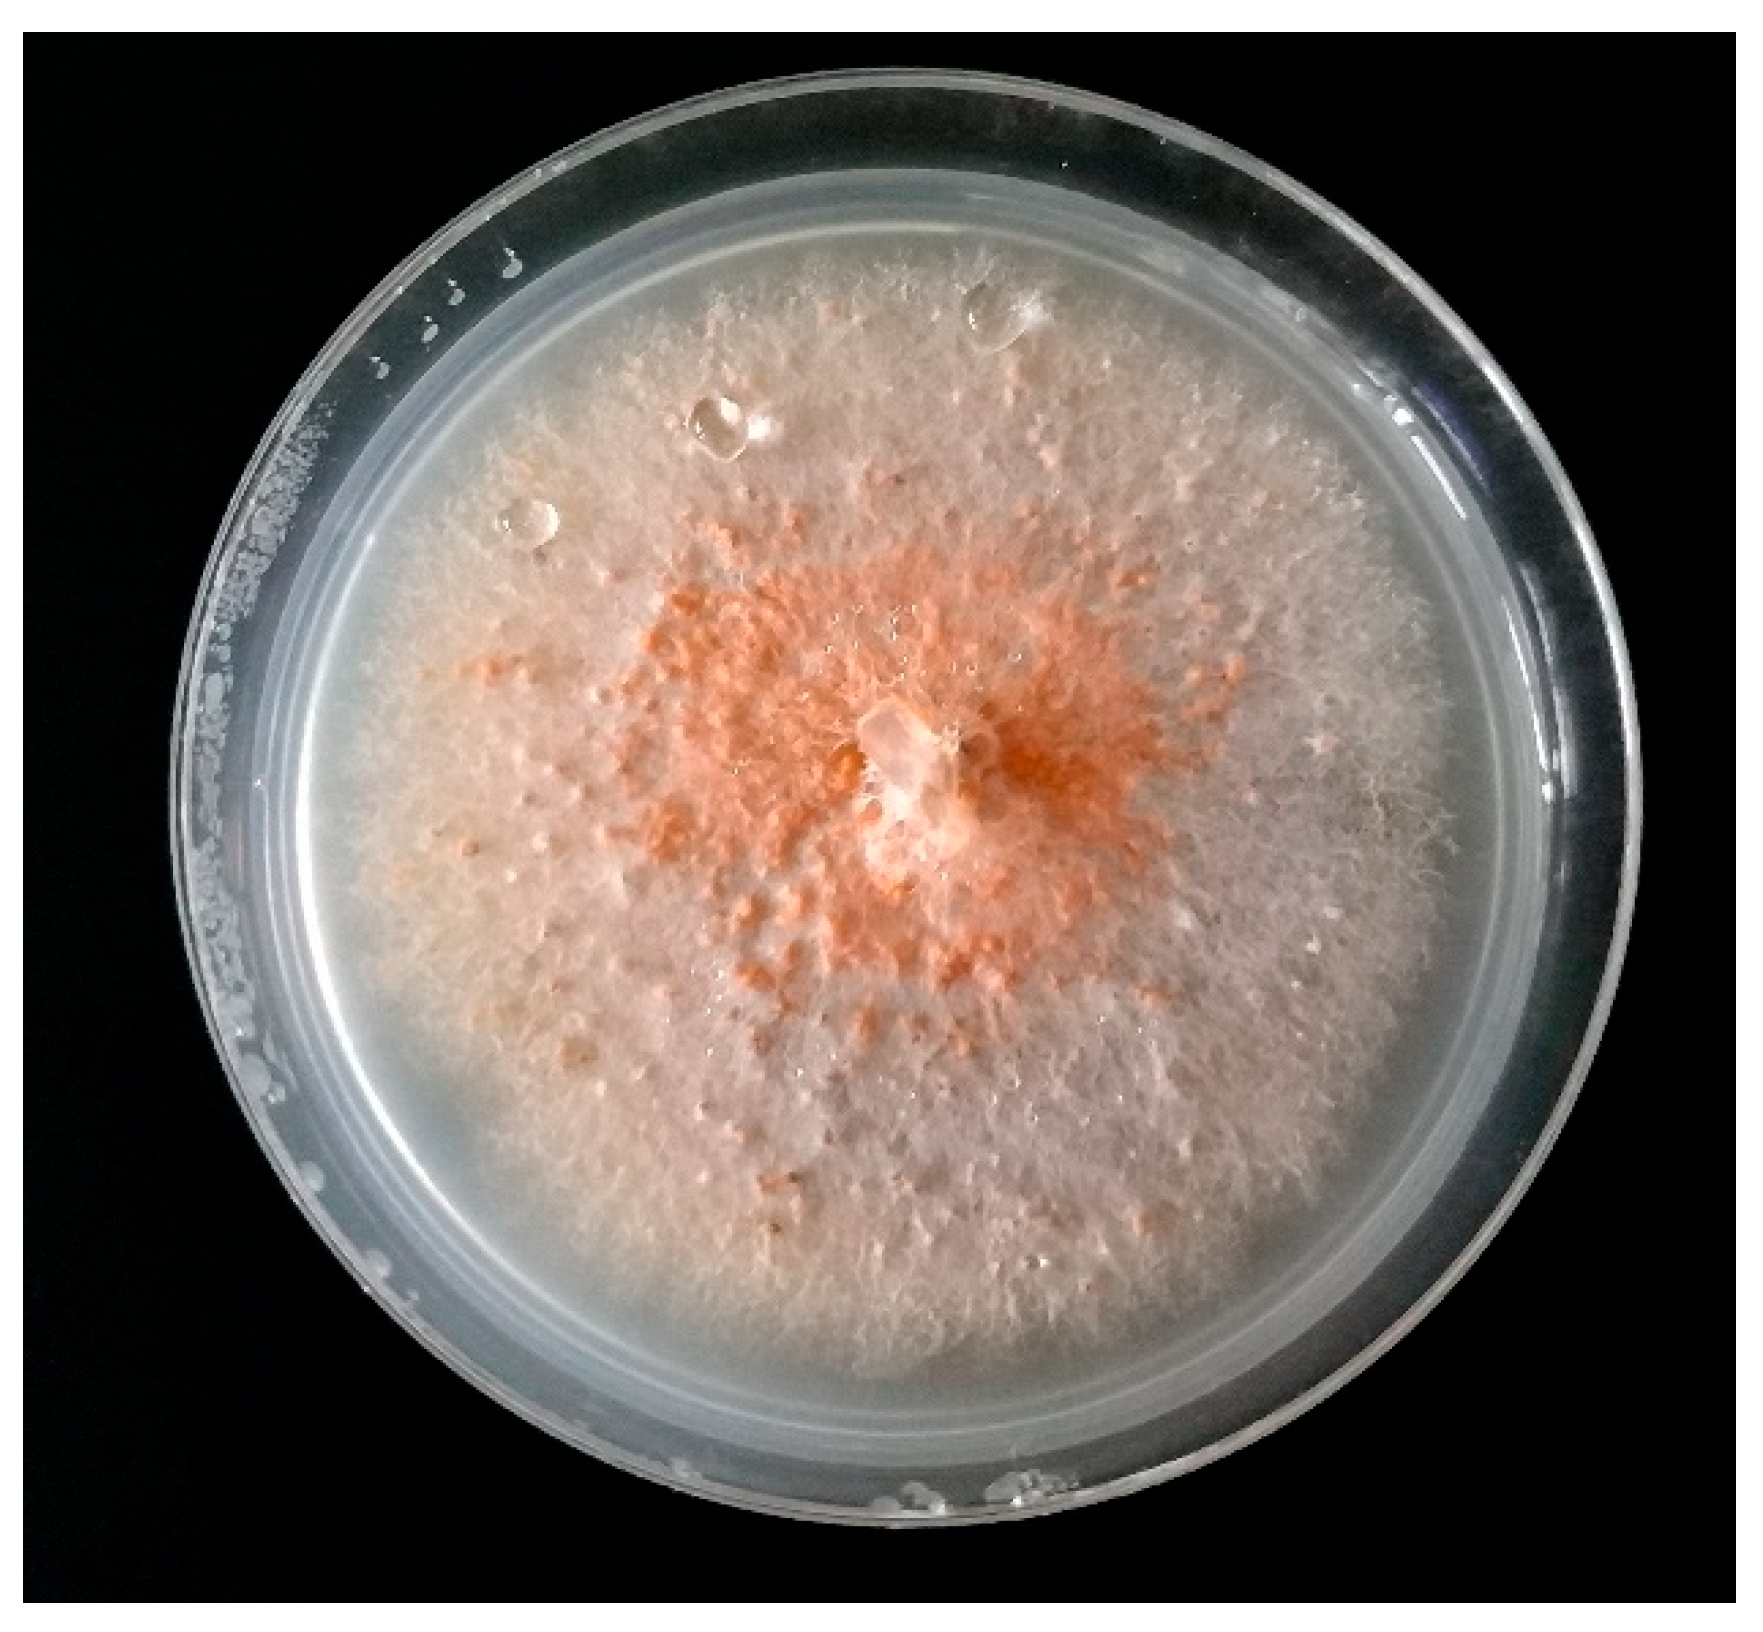
Molecules 24 01200 g004 Molecules 24 01200 g004

Alternative Molecular-Based Diagnostic Methods of Plant Pathogenic Fungi Affecting Berry Crops—A Review
Abstract
1. Introduction
2. Organic Plantations and Fungal Pathogens
3. Fungal Pathogens—Characteristics, Occurrence, Properties and Threats to Organic Farming
3.1. Verticillium spp.
3.2. Phytophthora spp.
3.3. Botrytis cinerea
3.4. Colletotrichum acutatum
4. Detection Methods of Plant Pathogenic Fungal Species
4.1. Traditional Methods
4.2. Molecular Methods
4.2.1. Verticillium spp.
4.2.2. Phytophthora spp.
4.2.3. Botrytis Cinerea
4.2.4. Colletotrichum acutatum
5. Summary and Future Challenges
Author Contributions
Funding
Conflicts of Interest
References
- Willer, H.; Lernoud, J.; Kemper, L. The world of organic agriculture 2018: Summary. In The World of Organic Agriculture. Statistics and Emerging Trends 2018; FiBL: Frick, Switzerland, 2018; pp. 22–33. [Google Scholar]
- FAOSTAT. Available online: http://www.fao.org/faostat/en/#data/QC (accessed on 7 November 2018).
- Lenroud, J.; Willer, H. Current statistics on organic agriculture worldwide: Area, operators and market. In The World of Organic Agriculture. Statistics and Emerging Trends 2018; FiBL: Frick, Switzerland, 2018; pp. 34–125. [Google Scholar]
- Brągiel, E.; Ślusarczyk, B. Tendencje na europejskim rynku żywności ekologicznej. Zesz. Nauk. Szk. Głównej Gospod. Wiej. Warszawie, Probl. Rol. Światowego 2017, 17, 29–38. [Google Scholar] [CrossRef]
- Sahota, A. The global market for organic food and drink. In The World of Organic Agriculture. Statistics and Emerging Trends 2018; FiBL: Frick, Switzerland, 2018; pp. 146–150. [Google Scholar]
- Palter, J.B. The role of the gulf stream in European climate. Ann. Rev. Mar. Sci. 2015, 7, 113–137. [Google Scholar] [CrossRef] [PubMed]
- Mertely, J.C.; Chandler, C.K.; Xiao, C.L.; Legard, D.E. Comparison of Sanitation and Fungicides for Management of Botrytis Fruit Rot of Strawberry. Plant Dis. 2007, 84, 1197–1202. [Google Scholar] [CrossRef] [PubMed]
- Prokkola, S.; Kivijärvi, P. Effect of biological sprays on the incidence of grey mould, fruit yield and fruit quality in organic strawberry production. Agric. Food Sci. 2007, 16, 25–33. [Google Scholar] [CrossRef]
- Spitzer, T.; Matušinsky, P. Detecting pathogens of Verticillium wilt in winter oilseed rape using ELISA and PCR-Comparison of the two methods and with visual stand evaluation. Acta Univ. Agric. Silvic. Mendelianae Brun. 2017, 65, 205–210. [Google Scholar] [CrossRef]
- Boff, P.; Kastelein, P.; de Kraker, J.; Gerlagh, M.; Kohl, J. Epidemiology of grey mould in annual waiting-bed production of strawberry. Eur. J. Plant Pathol. 2001, 107, 615–624. [Google Scholar] [CrossRef]
- Wilcox, W.F.; Seem, R.C. Relationship between strawberry gray mold incidence, environmental variables, and fungicide apllications during different periods of the fruiting season. Phytopathology 1994, 84, 264–270. [Google Scholar] [CrossRef]
- Lilja, A.T.; Parikka, P.; Pääskynkivi, E.A.; Hantula, J.I.; Vainio, E.J.; Vartiamäki, H.A.; Lemmetty, A.H.; Vestberg, M.V. Phytophthora cactorum and Colletotrichum acutatum: Survival and detection. Agric. Conspec. Sci. 2006, 71, 121–128. [Google Scholar]
- McCain, A.H.; Raabe, R.D.; Wilhelm, S. Plants Resistant or Susceptible to Verticillium Wilt; University of California: Oakland, CA, USA, 1981. [Google Scholar]
- Bhat, R.G.; Subbarao, K.V. Host range specificity in Verticillium dahliae. Phytopathology 1999, 89, 1218–1225. [Google Scholar] [CrossRef]
- Osbourn, A.E. Verticillium wilt of strawberry. PNAS 2001, 98, 14187–14188. [Google Scholar] [CrossRef]
- Inderbitzin, P.; Bostock, R.M.; Davis, R.M.; Usami, T.; Platt, H.W.; Subbarao, K.V. Phylogenetics and taxonomy of the fungal vascular wilt pathogen Verticillium, with the descriptions of five new species. PLoS ONE 2011, 6, e28341. [Google Scholar] [CrossRef]
- Goud, J.K.C.; Termorshuizen, A.J.; Gams, W. Morphology of Verticillium dahliae and V. tricorpus on semi-selective media used for the detection of V. dahliae in soil. Mycol. Res. 2003, 107, 822–830. [Google Scholar] [CrossRef] [PubMed]
- Goud, J.K.C.; Termorshuizen, A.J. Quality of methods to quantify microsclerotia of Verticillium dahliae in soil. Erupean J. Plant Pathol. 2003, 109, 523–534. [Google Scholar] [CrossRef]
- Yu, J.M.; Cafarov, I.H.; Babadoost, M. Morphology, molecular identity, and pathogenicity of Verticillium dahliae and V. longisporum sssociated with internally discolored horseradish roots. Plant Dis. 2016, 100, 749–757. [Google Scholar] [CrossRef] [PubMed]
- Özer, G.; Bayraktar, H. First report of Verticillium dahliae causing verticillium wilt on Goji berry in Turkey. J. Plant Pathol. 2016, 98, 682. [Google Scholar]
- Fradin, E.F.; Thomma, B.P.H.J. Physiology and molecular aspects of Verticillium wilt diseases caused by V. dahliae and V. albo-atrum. Mol. Plant Pathol. 2006, 7, 71–86. [Google Scholar] [CrossRef] [PubMed]
- Huang, L.; Mahoney, R.R. Purification and characterization of an endo- polygalacturonase from Verticillium albo-atrum. J. Appl. Microbiol. 1999, 86, 145–156. [Google Scholar] [CrossRef]
- Carder, J.H.; Hignett, R.C.; Swinburne, T.R. Relationship between the virulence of hop isolates of Verticillium albo-atrum and their in vitro secretion of cell-wall degrading enzymes. Physiol. Mol. Plant Pathol. 1987, 31, 441–452. [Google Scholar] [CrossRef]
- Barnes, E.H. Verticillium wilt. In Atlas and Manual of Plant Pathology; Plenum Press: New York, NY, USA, 1979; pp. 244–249. [Google Scholar]
- Martin, F.N.; Blair, J.E.; Coffey, M.D. A combined mitochondrial and nuclear multilocus phylogeny of the genus Phytophthora. Fungal Genet. Biol. 2014, 66, 19–32. [Google Scholar] [CrossRef]
- Dunstan, W.A.; Howard, K.; Stj Hardy, G.E.; Burgess, T.I. An overview of Australia’s Phytophthora species assemblage in natural ecosystems recovered from a survey in Victoria. IMA Fungus 2016, 7, 47–58. [Google Scholar] [CrossRef]
- Meszka, B.; Michalecka, M. Identification of Phytophthora spp. isolated from plants and soil samples on strawberry plantations in Poland. J. Plant Dis. Prot. 2016, 123, 29–36. [Google Scholar] [CrossRef]
- Wilcox, W.F.; Scott, P.H.; Hamm, P.B.; Kennedy, D.M.; Duncan, J.M.; Brasier, C.M.; Hansen, E.M. Identity of a Phytophthora species attacking raspberry in Europe and North America. Mycol. Res. 1993, 97, 817–831. [Google Scholar] [CrossRef]
- Weiland, J.E.; Benedict, C.; Zasada, I.A.; Scagel, C.R.; Beck, B.R.; Davis, A.; Graham, K.; Peetz, A.; Martin, R.R.; Dung, J.K.S.; et al. Late-summer disease symptoms in western washington red raspberry fields associated with co-occurrence of Phytophthora rubi, Verticillium dahliae and Pratylenchus penetrans, but not raspberry bushy dwarf virus. Plant Dis. 2018, 102, 938–947. [Google Scholar] [CrossRef]
- Gigot, J.; Walters, T.W.; Zasada, I.A. Impact and Occurrence of Phytophthora rubi and Pratylenchus penetrans in commercial red raspberry (Rubus ideaus) fields in Northwestern Washington. Int. J. Fruit Sci. 2013, 13, 357–372. [Google Scholar] [CrossRef]
- Martin, F.N.; Abad, Z.G.; Balci, Y.; Ivors, K. Identification and detection of Phytophthora: Reviewing our progress, identifying our needs. Plant Dis. 2012, 96, 1080–1103. [Google Scholar] [CrossRef]
- Dewey (Molly), F.M.; Yohalem, D. Detection, quantification and immunolocalisation of Bortytis species. In Botrytis: Biology, Pathology and Control; Kluwer Academic Publishers: Dordrecht, The Netherlands, 2007; pp. 181–194. [Google Scholar]
- Elad, Y.; Williamson, B.; Tudzynski, P.; Delent, N. Botrytis spp. and diseases they cause in agricultural systems—An introduction. In Botrytis: Biology, Pathology and Control; Kluwer Academic Publishers: Dordrecht, The Netherlands, 2007; pp. 1–6. [Google Scholar]
- Choquer, M.; Fournier, E.; Kunz, C.; Levis, C.; Pradier, J.-M.; Simon, A.; Viaud, M. Botrytis cinerea virulence factors: New insights into a necrotrophic and polyphageous pathogen. FEMS Microbiol. Lett. 2007, 277, 1–10. [Google Scholar] [CrossRef] [PubMed]
- Rasiukevičiūtė, N.; Rugienius, R.; Šikšnianienė, J.B. Genetic diversity of Botrytis cinerea from strawberry in Lithuania. Zemdirbyste-Agric. 2018, 105, 265–270. [Google Scholar] [CrossRef]
- Blanco, C.; De Los Santos, B.; Romero, F. Relationship between concentrations of Botrytis cinerea conidia in air, environmental conditions, and the incidence of grey mould in strawberry flowers and fruits. Eur. J. Plant Pathol. 2006, 114, 415–425. [Google Scholar] [CrossRef]
- Prusky, D. Pathogen quiescence in postharvest diseases. Annu. Rev. Phytopathol. 1996, 34, 413–434. [Google Scholar] [CrossRef]
- Dean, R.; Van Kan, J.A.L.; Pretorius, Z.A.; Hammond-Kosack, K.E.; Di Pietro, A.; Spanu, P.D.; Rudd, J.J.; Dickman, M.; Kahmann, R.; Ellis, J.; et al. The Top 10 fungal pathogens in molecular plant pathology. Mol. Plant Pathol. 2012, 13, 414–430. [Google Scholar] [CrossRef]
- Elad, Y. Responses of plants to infection by botrytis cinerea and novel means involved in reducing their susceptibility to infection. Biol. Rev. 1997, 72, 381–422. [Google Scholar] [CrossRef]
- Droby, S.; Lichter, A. Post-harvest Botrytis infection: Etiology, development and managment. In Botrytis: Biology, Pathology and Control; Kluwer Academic Publishers: Dordrecht, The Netherlands, 2007; pp. 349–368. [Google Scholar]
- Kozhar, O.; Peever, T.L. How does Botrytis cinerea infect red raspberry? Phytopathology 2018, 108, 1287–1298. [Google Scholar] [CrossRef]
- Xu, X.; Wedgwood, E.; Berrie, A.M.; Allen, J.; O’Neill, T.M. Management of raspberry and strawberry grey mould in open field and under protection. A review. Agron. Sustain. Dev. 2012, 32, 531–543. [Google Scholar] [CrossRef]
- Fitt, B.D.L.; Creighton, N.F.; Bainbridge, A. Role of wind and rain in dispersal of Botrytis fabae conidia. Trans. Br. Mycol. Soc. 1985, 85, 307–312. [Google Scholar] [CrossRef]
- Louis, C.; Girard, M.; Kuhl, G.; Lopez-Ferber, M. Persistence of Botrytis cinerea in its vector Drosophila melanogaster. Phytopathology 1996, 86, 934–939. [Google Scholar] [CrossRef]
- Doss, R.P. Composition and enzymatic activity of the extracellular matrix secreted by germlings of Botrytis cinerea. Appl. Environ. Microbiol. 1999, 65, 404–408. [Google Scholar] [PubMed]
- Nelson, K.E. Effect of humidity on infection of table grapes by Botrytis cinerea. Phytopathology 1951, 41, 859–864. [Google Scholar]
- Holz, G.; Coertze, S.; Williamson, B. The ecology of Botrytis on plant surfaces. In Botrytis: Biology, Pathology and Control; Kluwer Academic Publishers: Dordrecht, The Netherlands, 2007; pp. 9–28. [Google Scholar]
- Elmer, P.A.G.; Michailides, T.J. Epidemiology of Botrytis cinerea in orchard and vine crops. In Botrytis: Biology, Pathology and Control; Kluwer Academic Publishers: Dordrecht, The Netherlands, 2007. [Google Scholar]
- Rigotti, S.; Viret, O.; Gindro, K. Two new primers highly specific for the detection of Botrytis cinerea Pers.: Fr. Phytopathol. Mediterr. 2006, 45, 253–260. [Google Scholar]
- Khazaeli, P.; Zamanizadeh, H.; Morid, B.; Bayat, H. Morphological and molecular identification of Botrytis cinerea causal agent of gray mold in rose greenhouses in centeral regions of Iran. Int. J. Agric. Sci. Res. 2010, 1, 20–24. [Google Scholar]
- Whitelaw-Weckert, M.A.; Curtin, S.J.; Huang, R.; Steel, C.C.; Blanchard, C.L.; Roffey, P.E. Phylogenetic relationships and pathogenicity of Colletotrichum acutatum isolates from grape in subtropical Australia. Plant Pathol. 2007, 56, 448–463. [Google Scholar] [CrossRef]
- Garrido, C.; Carbú, M.; Fernández-Acero, F.J.; Vallejo, I.; Manuel Cantoral, J. Phylogenetic relationships and genome organisation of Colletotrichum acutatum causing anthracnose in strawberry. Eur. J. Plant Pathol. 2009, 125, 397–411. [Google Scholar] [CrossRef]
- Freeman, S.; Katan, T. Identification of Colletotrichum species responsible for anthracnose and root necrosis of strawberry in Israel. Phytopathology 1997, 87, 516–521. [Google Scholar] [CrossRef] [PubMed]
- Sonavane, P.; Venkataravanappa, V.; Reddy, M.K. First report of Collectotrichum acutatum associated with anthracnose disease in malayan apple from India. Plant Dis. 2017, 5, 465–472. [Google Scholar]
- Wagner, K.; Springer, B.; Pires, V.P.; Keller, P.M. Molecular detection of fungal pathogens in clinical specimens by 18S rDNA high-throughput screening in comparison to ITS PCR and culture. Sci. Rep. 2018, 8, 6964. [Google Scholar] [CrossRef]
- Liu, F.; Tang, G.; Zheng, X.; Li, Y.; Sun, X.; Qi, X.; Zhou, Y.; Xu, J.; Chen, H.; Chang, X.; et al. Molecular and phenotypic characterization of Colletotrichum species associated with anthracnose disease in peppers from Sichuan Province, China. Sci. Rep. 2016, 6, 1–17. [Google Scholar] [CrossRef]
- Debode, J.; van Hemelrijck, W.; Xu, X.M.; Maes, M.; Creemers, P.; Heungens, K. Latent entry and spread of Colletotrichum acutatum (species complex) in strawberry fields. Plant Pathol. 2015, 64, 385–395. [Google Scholar] [CrossRef]
- Madden, L.V.; Yang, X.; Wilson, L.L. Effects of rain intensity on splash dispersal of Colletoreichum acutatum. Phytopathology 1996, 86, 864–874. [Google Scholar] [CrossRef]
- Eastburn, D.M.; Gubler, W.D. Strawberry anthracnose: Detection and survival of Colletotrichum acutatum in soil. Plant Dis. 1990, 74, 161–163. [Google Scholar] [CrossRef]
- Narayanasamy, P. Detection of fungal pathogens in plants. In Microbial Plant Pathogens—Detection and Disease Diagnosis: Fungal Pathogens; Springer Science + Business Media B.V.: Berlin, Germany, 2011; Volume 1, pp. 5–199. ISBN 9789048197682. [Google Scholar]
- Larkin, R.P.; Ristaino, J.B.; Campbell, L.C. Detection and quantification of Phytophthora capsici in soil. Am. Phytopathol. Soc. 1995, 85, 1057–1063. [Google Scholar] [CrossRef]
- Frąc, M.; Jezierska-Tys, S.; Yaguchi, T. Occurrence, detection, and molecular and metabolic characterization of heat-resistant fungi in soils and plants and their risk to human health. Adv. Agron. 2015, 132, 161–204. [Google Scholar]
- Edwards, S.G.; Seddon, B. Selective media for thw specific isolatiotion and enumeration of Botrytis cinerea conidia. Lett. Appl. Microbiol. 2001, 32, 63–66. [Google Scholar] [CrossRef]
- Arbefeville, S.; Harris, A.; Ferrieri, P. Comparison of sequencing the D2 region of the large subunit ribosomal RNA gene (MicroSEQ®) versus the internal transcribed spacer (ITS) regions using two public databases for identification of common and uncommon clinically relevant fungal species. J. Microbiol. Methods 2017, 140, 40–46. [Google Scholar] [CrossRef]
- Panek, J.; Frąc, M. Development of a qPCR assay for the detection of heat-resistant Talaromyces flavus. Int. J. Food Microbiol. 2018, 270, 44–51. [Google Scholar] [CrossRef] [PubMed]
- Capote, N.; Pastrana, M.A.; Aguado, A.; Sanchez-Torres, P. Molecular tools for detection of plant pathogenic fungi and fungicide resistance. In Plant pathology; IntechOpen: London, UK, 2012. [Google Scholar]
- Saiki, R.K.; Stoffel, S.; Scharf, S.J.; Higuchi, R.; Horn, G.T.; Mullis, K.B.; Erlich, H.A. Primer-directed enzymatic amplification of DNA with a thermostable DNA polymerase. Science 1988, 239, 487–491. [Google Scholar] [CrossRef] [PubMed]
- Higuchi, R.; Dollinger, G.; Walsh, S.P.; Griffith, R. Simultaneous amplification and detection of specific DNA sequences. Nat. Biotechnol. 1992, 10, 413–417. [Google Scholar] [CrossRef]
- Higuchi, R.; Fockler, C.; Dollinger, G.; Watson, R. Kinectic PCR analysis: Real-time monitoring of DNA amplification reactions. Nat. Biotechnol. 1993, 11, 1026–1030. [Google Scholar] [CrossRef]
- Garrido, C.; Carbú, M.; Fernández-Acero, F.J.; Boonham, N.; Colyer, A.; Cantoral, J.M.; Budge, G. Development of protocols for detection of Colletotrichum acutatum and monitoring of strawberry anthracnose using real-time PCR. Plant Pathol. 2009, 58, 43–51. [Google Scholar] [CrossRef]
- Notomi, T.; Okayama, H.; Masubuchi, H.; Yonekawa, T.; Watanabe, K.; Amino, N.; Hase, T. Loop mediated isothermal amplification of DNA. Nucleic Acids Res. 2000, 28, e63. [Google Scholar] [CrossRef]
- Francois, P.; Tangomo, M.; Hibbs, J.; Bonetti, E.J.; Boehme, C.C.; Notomi, T.; Perkins, M.D.; Schrenzel, J. Robustness of a loop-mediated isothermal amplification reaction for diagnostic applications. FEMS Immunol. Med. Microbiol. 2011, 62, 41–48. [Google Scholar] [CrossRef]
- Niessen, L. Current state and future perspectives of loop-mediated isothermal amplification (LAMP)-based diagnosis of filamentous fungi and yeasts. Appl. Microbiol. Biotechnol. 2014, 99, 553–574. [Google Scholar] [CrossRef]
- Metzker, M.L. Sequencing technologies the next generation. Nat. Rev. Genet. 2010, 11, 31–46. [Google Scholar] [CrossRef] [PubMed]
- Faino, L.; Thomma, B.P.H.J. Get your high-quality low-cost genome sequence. Trends Plant Sci. 2014, 19, 288–291. [Google Scholar] [CrossRef]
- Panek, J.; Frąc, M.; Bilińska-Wielgus, N. Comparison of chemical sensitivity of fresh and long-stored heat resistant Neosartorya fischeri environmental isolates using Biolog Phenotype MicroArray system. PLoS ONE 2016, 11, e0147605. [Google Scholar] [CrossRef] [PubMed]
- Diguta, C.F.; Vincent, B.; Guilloux-Benatier, M.; Alexandre, H.; Rousseaux, S. PCR ITS-RFLP: A useful method for identifying filamentous fungi isolates on grapes. Food Microbiol. 2011, 28, 1145–1154. [Google Scholar] [CrossRef] [PubMed]
- Krupa, P. Identification by PCR-RFLP of a fungus isolated from mycorrhizal roots of a distinguishable birch growing in areas disturbed by industry. Polish J. Environ. Stud. 1999, 8, 161–163. [Google Scholar]
- Inderbitzin, P.; Davis, R.M.; Bostock, R.M.; Subbarao, K.V. Identification and differentiation of Verticillium species and V. longisporum lineages by simplex and multiplex PCR assays. PLoS ONE 2013, 8, e65990. [Google Scholar] [CrossRef]
- Lievens, B.; Brouwer, M.; Vanachter, A.C.R.C.; Cammue, B.P.A.; Thomma, B.P.H.J. Real-time PCR for detection and quantification of fungal and oomycete tomato pathogens in plant and soil samples. Plant Sci. 2006, 171, 155–165. [Google Scholar] [CrossRef]
- Ozyilmaz, U.; Benlioglu, K.; Yildiz, A.; Benlioglu, H.S. Effects of soil amendments combined with solarization on the soil microbial community in strawberry cultivation using quantitative real-time PCR. Phytoparasitica 2016, 44, 661–680. [Google Scholar] [CrossRef]
- Mirmajlessi, S.M.; Larena, I.; Mänd, M.; Loit, E. A rapid diagnostic assay for detection and quantification of the causal agent of strawberry wilt from field samples. Acta Agric. Scand. Sect. B — Soil Plant Sci. 2016, 66, 619–629. [Google Scholar] [CrossRef]
- Debode, J.; van Poucke, K.; França, S.C.; Maes, M.; Höfte, M.; Heungens, K. Detection of multiple Verticillium species in soil using density flotation and real-time polymerase chain reaction. Plant Dis. 2011, 95, 1571–1580. [Google Scholar] [CrossRef]
- O’Donnell, K.; Cigelnik, E. Two divergent intragenomic rDNA ITS2 types within a monophyletic lineage of the fungus Fusarium are nonorthologous. Mol. Phylogenet. Evol. 1997, 7, 103–116. [Google Scholar] [CrossRef] [PubMed]
- Knüfer, J.; Lopisso, D.T.; Koopmann, B.; Karlovsky, P.; von Tiedemann, A. Assessment of latent infection with Verticillium longisporum in field-grown oilseed rape by qPCR. Eur. J. Plant Pathol. 2017, 147, 819–831. [Google Scholar] [CrossRef]
- Klosterman, S.J. Real-Time PCR for the Quantification of Fungi in Planta; Springer: Berlin, Germany, 2012; Volume 835, pp. 121–132. ISBN 9781617795008. [Google Scholar]
- Bilodeau, G.J.; Koike, S.T.; Uribe, P.; Martin, F.N. Development of an assay for rapid detection and quantification of Verticillium dahliae in soil. Phytopathology 2012, 102, 331–343. [Google Scholar] [CrossRef]
- Pasche, J.S.; Mallik, I.; Anderson, N.R.; Gudmestad, N.C. Development and validation of a real-time PCR assay for the quantification of Verticillium dahliae in potato. Plant Dis. 2013, 97, 608–618. [Google Scholar] [CrossRef]
- Pasche, J.S.; Thompson, A.L.; Gudmestad, N.C. Quantification of field resistance to Verticillium dahliae in eight russet-skinned potato cultivars using real-time PCR. Am. J. Potato Res. 2013, 90, 158–170. [Google Scholar] [CrossRef]
- Tzelepis, G.; Bejai, S.; Sattar, M.N.; Schwelm, A.; Ilbäck, J.; Fogelqvist, J.; Dixelius, C. Detection of Verticillium species in Swedish soils using real-time PCR. Arch. Microbiol. 2017, 199, 1383–1389. [Google Scholar] [CrossRef] [PubMed]
- White, T.J.; Bruns, T.; Lee, S.; Taylor, J. Amplification and direct sequencing of fungal ribosomal RNA genes for phylogenetics. PCR Protoc. A Guid. to Methods Appl. 1990, 18, 315–322. [Google Scholar]
- Pantou, M.P.; Mavridou, A.; Typas, M.A. IGS sequence variation, group-I introns and the complete nuclear ribosomal DNA of the entomopathogenic fungus Metarhizium: Excellent tools for isolate detection and phylogenetic analysis. Fungal Genet. Biol. 2003, 38, 159–174. [Google Scholar] [CrossRef]
- Eynck, C.; Koopmann, B.; Grunewaldt-Stoecker, G.; Karlovsky, P.; von Tiedemann, A. Differential interactions of Verticillium longisporum and V. dahliae with Brassica napus detected with molecular and histological techniques. Eur. J. Plant Pathol. 2007, 118, 259–274. [Google Scholar] [CrossRef]
- Borza, T.; Beaton, B.; Govindarajan, A.; Gao, X.; Liu, Y.; Ganga, Z.; Wang-Pruski, G. Incidence and abundance of Verticillium dahliae in soil from various agricultural fields in Prince Edward Island, Canada. Eur. J. Plant Pathol. 2018, 151, 825–830. [Google Scholar] [CrossRef]
- Moradi, A.; Almasi, M.A.; Jafary, H.; Mercado-Blanco, J. A novel and rapid loop-mediated isothermal amplification assay for the specific detection of Verticillium dahliae. J. Appl. Microbiol. 2014, 116, 942–954. [Google Scholar] [CrossRef] [PubMed]
- De Jonge, R.; Bolton, M.D.; Kombrink, A.; van Den Berg, G.C.M.; Yadeta, K.A.; Thomma, B.P.H.J. Extensive chromosomal reshuffling drives evolution of virulence in an asexual pathogen. Genome Res. 2013, 23, 1271–1282. [Google Scholar] [CrossRef]
- Faino, L.; Seidl, M.F.; Datema, E.; van den Berg, G.C.M.; Janssen, A.; Wittenberg, A.H.J.; Thomma, B.P.H.J. Single-molecule real-time sequencing combined with optical mapping yields completely finished fungal genome. MBio 2015, 6, e00936-15. [Google Scholar] [CrossRef]
- Fan, R.; Cockerton, H.M.; Armitage, A.D.; Bates, H.; Cascant-Lopez, E.; Antanaviciute, L.; Xu, X.; Hu, X.; Harrison, R.J. Vegetative compatibility groups partition variation in the virulence of Verticillium dahliae on strawberry. PLoS ONE 2018, 13, 1–21. [Google Scholar] [CrossRef]
- Jelen, V.; De Jonge, R.; van De Peer, Y.; Javornik, B.; Jakše, J. Complete mitochondrial genome of the Verticillium wilt causing plant pathogen Verticillium nonalfalfae. PLoS ONE 2016, 11. [Google Scholar] [CrossRef]
- Fogelqvist, J.; Tzelepis, G.; Bejai, S.; Ilbäck, J.; Schwelm, A.; Dixelius, C. Analysis of the hybrid genomes of two field isolates of the soil-borne fungal species Verticillium longisporum. BMC Genom. 2018, 19, 1–12. [Google Scholar] [CrossRef] [PubMed]
- Cooke, D.E.L.; Duncan, J.M. Phylogenetic analysis of Phytophthora species based on ITS1 and ITS2 sequences of the ribosomal RNA gene repeat. Mycol. Res. 1997, 101, 667–677. [Google Scholar] [CrossRef]
- Ristaino, J.B.; Madritch, M.; Trout, C.; Parra, G. PCR amplification of ribosomal DNA for species identification of Phytophthora. Appl. Environ. Microbiol. 1998, 64, 948–954. [Google Scholar] [PubMed]
- Cooke, D.E.L.; Drenth, A.; Duncan, J.M.; Wagels, G.; Brasier, C.M. A molecular phylogeny of phytophthora and related oomycetes. Fungal Genet. Biol. 2000, 30, 17–32. [Google Scholar] [CrossRef] [PubMed]
- Martin, F.N.; Tooley, P.W.; Blomquist, C. Molecular detection of Phytophthora ramorum, the causal agent of sudden oak death in California, and two additional species commonly recovered from diseased plant material. Phytopathology 2004, 94, 621–631. [Google Scholar] [CrossRef] [PubMed]
- Polashock, J.J.; Vaiciunas, J.; Oudemans, P.V. Identification of a new Phytophthora species causing root and runner rot of cranberry in New Jersey. Phytopathology 2005, 95, 1237–1243. [Google Scholar] [CrossRef] [PubMed]
- Blair, J.E.; Coffey, M.D.; Park, S.-Y.; Geiser, D.M.; Kang, S. A multi-locus phylogeny for Phytophthora utilizing markers derived from complete genome sequences. Fungal Genet. Biol. 2008, 45, 266–277. [Google Scholar] [CrossRef] [PubMed]
- Bienapfl, J.C.; Balci, Y. Movement of Phytophthora spp. in Maryland’s Nursery Trade. Plant Dis. 2014, 98, 134–144. [Google Scholar] [CrossRef] [PubMed]
- Böhm, J.; Hahn, A.; Schubert, R.; Bahnweg, G.; Adler, N.; Nechwatal, J.; Oehlmann, R.; Oßwald, W.F. Real-time quantitative PCR: DNA determination in isolated spores of the mycorrhizal fungus Glomus mosseae and monitoring of Phytophthora infestans and Phytophthora citricola in their respective host plants. Phytopathology 1999, 147, 409–416. [Google Scholar] [CrossRef]
- Kox, L.F.F.; Van Brouwershaven, I.R.; Van De Vossenberg, B.T.L.H.; Van den Beld, H.E.; Bonants, P.J.M.; de Gruyter, J. Diagnostic values and utility of immunological, morphological, and molecular methods for in planta detection of Phytophthora ramorum. Phytopathology 2007, 97, 1119–1129. [Google Scholar] [CrossRef]
- Pastrana, A.M.; Basallote-Ureba, M.J.; Aguado, A.; Capote, N. Potential inoculum sources and incidence of strawberry soilborne pathogens in Spain. Plant Dis. 2017, 101, 751–760. [Google Scholar] [CrossRef]
- Nath, V.S.; Hegde, V.M.; Jeeva, M.L.; Misra, R.S.; Veena, S.S.; Raj, M.; Unnikrishnan, S.K.; Darveekaran, S.S. Rapid and sensitive detection of Phytophthora colocasiae responsible for the taro leaf blight using conventional and real-time PCR assay. FEMS Microbiol. Lett. 2014, 352, 174–183. [Google Scholar] [CrossRef]
- Li, M.; Inada, M.; Watanabe, H.; Suga, H.; Kageyama, K. Simultaneous detection and quantification of Phytophthora nicotianae and P. cactorum, and distribution analyses in strawberry greenhouses by duplex real-time PCR. Microbes Environ. 2013, 28, 195–203. [Google Scholar] [CrossRef]
- Liao, F.; Zhang, Y.; Zhu, L.-H.; Cao, B.; Lv, D.; Luo, J.-F.; Li, G.-R. Triplex real-time PCR detection of three quarantine Phytophthora pathogens infecting Malus Miller. J. Plant Dis. Prot. 2018, 125, 325–330. [Google Scholar] [CrossRef]
- Martin, F.N.; Tooley, P.W. Phylogenetic relationships among Phytophthora species inferred from sequence analysis of mitochondrially encoded cytochrome oxidase I and II genes. Mycologia 2003, 95, 269–284. [Google Scholar] [CrossRef] [PubMed]
- Ioos, R.; Andrieux, A.; Marçais, B.; Frey, P. Genetic characterization of the natural hybrid species Phytophthora alni as inferred from nuclear and mitochondrial DNA analyses. Fungal Genet. Biol. 2006, 43, 511–529. [Google Scholar] [CrossRef] [PubMed]
- Tomlinson, J.A.; Barker, I.; Boonham, N. Faster, simpler, more-specific methods for improved molecular detection of Phytophthora ramorum in the field. Appl. Environ. Microbiol. 2007, 73, 4040–4047. [Google Scholar] [CrossRef] [PubMed]
- Chen, Q.; Li, B.; Liu, P.; Lan, C.; Zhan, Z.; Weng, Q. Development and evaluation of specific PCR and LAMP assays for the rapid detection of Phytophthora melonis. Eur. J. Plant Pathol. 2013, 137, 597–607. [Google Scholar] [CrossRef]
- Si Ammour, M.; Bilodeau, G.J.; Tremblay, D.M.; van der Heyden, H.; Yaseen, T.; Varvaro, L.; Carisse, O. Development of real-time isothermal amplification assays for on-site detection of Phytophthora infestans in potato leaves. Plant Dis. 2017, 101, 1269–1277. [Google Scholar] [CrossRef]
- Khan, M.; Li, B.; Jiang, Y.; Weng, Q.; Chen, Q. Evaluation of different PCR-based assays and LAMP method for rapid detection of Phytophthora infestans by targeting the Ypt1 gene. Front. Microbiol. 2017, 8, 1–11. [Google Scholar] [CrossRef] [PubMed]
- Tyler, B.M.; Tripathy, S.; Zhang, X.; Dehal, P.; Jiang, R.H.Y.; Aerts, A.; Arredondo, F.D.; Baxter, L.; Bensasson, D.; Beynon, J.L.; et al. Phytophthora genome sequences uncover evolutionary origins and mechanisms of pathogenesis. Science 2006, 313, 1261–1266. [Google Scholar] [CrossRef] [PubMed]
- Haas, B.J.; Kamoun, S.; Zody, M.C.; Jiang, R.H.Y.; Handsaker, R.E.; Cano, L.M.; Grabherr, M.; Kodira, C.D.; Raffaele, S.; Torto-Alalibo, T.; et al. Genome sequence and analysis of the Irish potato famine pathogen Phytophthora infestans. Nature 2009, 461, 393–398. [Google Scholar] [CrossRef]
- Tabima, J.F.; Kronmiller, B.A.; Press, C.M.; Tyler, B.M.; Zasada, I.A.; Grünwald, N.J. Whole genome sequences of the raspberry and strawberry pathogens Phytophthora rubi and P. fragariae. Mol. Plant-Microbe Interact. 2017, 30, 767–769. [Google Scholar] [CrossRef]
- Rigotti, S.; Gindro, K.; Richter, H.; Viret, O. Characterization of molecular markers for specific and sensitive detection of Botrytis cinerea Pers.: Fr. In strawberry (Fragaria×ananassa Duch.) using PCR. FEMS Microbiol. Lett. 2002, 209, 169–174. [Google Scholar] [CrossRef]
- Fan, X.; Zhang, J.Z.; Yang, L.; Wu, M.; Chen, W.; Li, G. Development of PCR-based assays for detecting and differentiating three species of Botrytis infecting broad bean. Plant Dis. 2015, 99, 691–698. [Google Scholar] [CrossRef]
- Kamaruzzaman, M.; Hao, F.; Wu, M.; Li, G. Gray mold of strawberry (Fragaria ananassa) caused by a rare pink-colored isolate of Botrytis cinerea in China. Australas. Plant Pathol. 2018, 47, 587–589. [Google Scholar] [CrossRef]
- Kim, J.Y.; Aktaruzzaman, M.; Afroz, T.; Kim, B.S.; Shin, H.D. First report of gray mold caused by Botrytis cinerea on red raspberry (Rubus idaeus) in Korea. Plant Dis. 2016, 100, 533. [Google Scholar] [CrossRef]
- Wang, H.C.; Li, L.C.; Cai, B.; Cai, L.T.; Chen, X.J.; Yu, Z.H.; Zhang, C.Q. Metabolic phenotype characterization of Botrytis cinerea, the causal agent of gray mold. Front. Microbiol. 2018, 9, 1–9. [Google Scholar] [CrossRef]
- Alam, M.W.; Gleason, M.L.; Malik, A.U.; Amin, M.; Fiaz, M.; Ali, S.; Rosli, H.; Rehman, A. First report of Botrytis spp. as a postharvest pathogen of strawberry in Pakistan. J. Plant Pathol. 2017, 99, 287–304. [Google Scholar]
- Garibaldi, A.; Bertetti, D.; Ortega, S.F.; Pensa, P.; Gullino, M.L. First report of Botrytis blight caused by Botrytis cinerea on Helichrysum bracteatum in Italy. J. Plant Pathol. 2018, 99, 287–304. [Google Scholar]
- Brouwer, M.; Lievens, B.; van Hemelrijck, W.; van Den Ackerveken, G.; Cammue, B.P.A.; Thomma, B.P.H.J. Quantification of disease progression of several microbial pathogens on Arabidopsis thaliana using real-time fluorescence PCR. FEMS Microbiol. Lett. 2003, 228, 241–248. [Google Scholar] [CrossRef]
- Gachon, C.; Saindrenan, P. Real-time PCR monitoring of fungal development in Arabidopsis thaliana infected by Alternaria brassicicola and Botrytis cinerea. Plant Physiol. Biochem. 2004, 42, 367–371. [Google Scholar] [CrossRef]
- Suarez, M.B.; Walsh, K.; Boonham, N.; O’Neill, T.M.; Pearson, S.; Barker, I. Development of real-time PCR (TaqMan®) assays for the detection and quantification of Botrytis cinerea in planta. Plant Physiol. Biochem. 2005, 43, 890–899. [Google Scholar] [CrossRef] [PubMed]
- Reich, J.D.; Alexander, T.W.; Chatterton, S. A multiplex PCR assay for the detection and quantification of Sclerotinia sclerotiorum and Botrytis cinerea. Lett. Appl. Microbiol. 2016, 62, 379–385. [Google Scholar] [CrossRef]
- Zhang, X.; Xie, F.; Lv, B.; Zhao, P.; Ma, X. Suspension array for multiplex detection of eight fungicide-resistance related alleles in Botrytis cinerea. Front. Microbiol. 2016, 7, 1–10. [Google Scholar] [CrossRef] [PubMed]
- Staats, M.; van Baarlen, P.; van Kan, J.A.L. Molecular phylogeny of the plant pathogenic genus Botrytis and the evolution of host specificity. Mol. Biol. Evol. 2005, 22, 333–346. [Google Scholar] [CrossRef]
- Fournier, E.; Levis, C.; Fortini, D.; Leroux, P.; Giraud, T.; Brygoo, Y. Characterization of Bc-hch, the Botrytis cinerea homolog of the Neurospora crassa het-c vegetative incompatibility locus, and its use as a population marker. Mycologia 2003, 95, 251–261. [Google Scholar] [CrossRef]
- Fournier, E.; Giraud, T.; Loiseau, A.; Vautrin, D.; Estoup, A.; Solignac, M.; Cornuet, J.M.; Brygoo, Y. Characterization of nine polymorphic microsatellite loci in the fungus Botrytis cinerea (Ascomycota). Mol. Ecol. Notes 2002, 2, 253–255. [Google Scholar] [CrossRef]
- Tomlinson, J.A.; Dickinson, M.J.; Boonham, N. Detection of Botrytis cinerea by loop-mediated isothermal amplification. Lett. Appl. Microbiol. 2010, 51, 650–657. [Google Scholar] [CrossRef] [PubMed]
- Duan, Y.B.; Ge, C.Y.; Zhang, X.K.; Wang, J.X.; Zhou, M.G. Development and evaluation of a novel and rapid detection assay for Botrytis cinerea based on loop-mediated isothermal amplification. PLoS ONE 2014, 9. [Google Scholar] [CrossRef]
- Duan, Y.B.; Yang, Y.; Li, M.X.; Li, T.; Fraaije, B.A.; Zhou, M.G. Development and application of a simple, rapid and sensitive method for detecting moderately carbendazim-resistant isolates in Botrytis cinerea. Ann. Appl. Biol. 2018, 172, 355–365. [Google Scholar] [CrossRef]
- Duan, Y.B.; Yang, Y.; Wang, J.X.; Chen, C.J.; Steinberg, G.; Fraaije, B.A.; Zhou, M.G. Simultaneous detection of multiple benzimidazole-resistant β-tubulin variants of Botrytis cinerea using loop-mediated isothermal amplification. Plant Dis. 2018, 102, 2016–2024. [Google Scholar] [CrossRef] [PubMed]
- Hu, X.R.; Dai, D.J.; Wang, H.D.; Zhang, C.Q. Rapid on-site evaluation of the development of resistance to quinone outside inhibitors in Botrytis cinerea. Sci. Rep. 2017, 7, 1–9. [Google Scholar] [CrossRef]
- Amselem, J.; Cuomo, C.A.; van Kan, J.A.L.; Viaud, M.; Benito, E.P.; Couloux, A.; Coutinho, P.M.; de Vries, R.P.; Dyer, P.S.; Fillinger, S.; et al. Genomic analysis of the necrotrophic fungal pathogens sclerotinia sclerotiorum and Botrytis cinerea. PLoS Genet. 2011, 7, e1002230. [Google Scholar] [CrossRef] [PubMed]
- Staats, M.; van Kan, J.A.L. Genome update of Botrytis cinerea strains B05.10 and T4. Eukaryot. Cell 2012, 11, 1413–1414. [Google Scholar] [CrossRef]
- van Kan, J.A.L.; Stassen, J.H.M.; Mosbach, A.; van Der Lee, T.A.J.; Faino, L.; Farmer, A.D.; Papasotiriou, D.G.; Zhou, S.; Seidl, M.F.; Cottam, E.; et al. A gapless genome sequence of the fungus Botrytis cinerea. Mol. Plant Pathol. 2017, 18, 75–89. [Google Scholar] [CrossRef] [PubMed]
- Polashock, J.J.; Caruso, F.L.; Oudemans, P.V.; McManus, P.S.; Crouch, J.A. The North American cranberry fruit rot fungal community: A systematic overview using morphological and phylogenetic affinities. Plant Pathol. 2009, 58, 1116–1127. [Google Scholar] [CrossRef]
- van Hemelrijck, W.; Debode, J.; Heungens, K.; Maes, M.; Creemers, P. Phenotypic and genetic characterization of Colletotrichum isolates from Belgian strawberry fields. Plant Pathol. 2010, 59, 853–861. [Google Scholar] [CrossRef]
- Xie, L.; Zhang, J.Z.; Wan, Y.; Hu, D. Identification of Colletotrichum spp. isolated from strawberry in Zhejiang Province and Shanghai City, China. J. Zhejiang Univ. Sci. B 2010, 11, 61–70. [Google Scholar] [CrossRef] [PubMed]
- Liu, B.; Louws, F.J.; Sutton, T.B.; Correll, J.C. A rapid qualitative molecular method for the identification of Colletotrichum acutatum and C. gloeosporioides. Eur. J. Plant Pathol. 2012, 132, 593–607. [Google Scholar] [CrossRef]
- Shivas, R.G.; Tan, Y.P. A taxonomic re-assesment of Colletotrichum acutatum, introducing C. fioriniae comb. at stat. nov. and C. simmondsii sp. nov. Fungal Divers. 2009, 111–122. [Google Scholar]
- Han, Y.C.; Zeng, X.G.; Xiang, F.Y.; Chen, F.Y.; Gu, Y.C. Distribution and characteristics of Colletotrichum spp. associated with anthracnose of strawberry in Hubei, China. Plant Dis. 2016, 100, 996–1006. [Google Scholar] [CrossRef] [PubMed]
- Forcelini, B.B.; Seijo, T.E.; Amiri, A.; Peres, N.A. Resistance in strawberry isolates of Colletotrichum acutatum from Florida to quinone-outside inhibitor fungicides. Plant Dis. 2016, 100, 2050–2056. [Google Scholar] [CrossRef] [PubMed]
- Debode, J.; van Hemelrijck, W.; Baeyen, S.; Creemers, P.; Heungens, K.; Maes, M. Quantitative detection and monitoring of Colletotrichum acutatum in strawberry leaves using real-time PCR. Plant Pathol. 2009, 58, 504–514. [Google Scholar] [CrossRef]
- Schena, L.; Abdelfattah, A.; Mosca, S.; Li Destri Nicosia, M.G.; Agosteo, G.E.; Cacciola, S.O. Quantitative detection of Colletotrichum godetiae and C. acutatum sensu stricto in the phyllosphere and carposphere of olive during four phenological phases. Eur. J. Plant Pathol. 2017, 149, 337–347. [Google Scholar] [CrossRef]
- Vilgalys, R.; Hester, M. Rapid genetic identification and mapping of anzymatically amplified ribosomal DNA from several Cryptococcus species. J. Bacteriol. 1990, 172, 4238–4246. [Google Scholar] [CrossRef] [PubMed]
- Martinez-Culebras, P.V.; Querol, A.; Suarez-Fernandez, M.B.; Garcia-Lopez, M.D.; Barrio, E. Phylogenetic relationships among Colletotrichum pathogens of strawberry and design of PCR primers for their identification. J. Phytopathol. 2003, 151, 135–143. [Google Scholar] [CrossRef]
- Weir, B.S.; Johnston, P.R.; Damm, U. The Colletotrichum gloeosporioides species complex. Stud. Mycol. 2012, 73, 115–180. [Google Scholar] [CrossRef]
- Zhang, X.; Harrington, T.C.; Batzer, J.C.; Kubota, R.; Peres, N.A.; Gleason, M.L. Detection of Colletotrichum acutatum sensu lato on strawberry by Loop-Mediated Isothermal Amplification. Plant Dis. 2016, 100, 1804–1812. [Google Scholar] [CrossRef]
- Han, J.H.; Chon, J.K.; Ahn, J.H.; Choi, I.Y.; Lee, Y.H.; Kim, K.S. Whole genome sequence and genome annotation of Colletotrichum acutatum, causal agent of anthracnose in pepper plants in South Korea. Genomics Data 2016, 8, 45–46. [Google Scholar] [CrossRef]
- Frąc, M.; Hannula, S.E.; Belka, M.; Jȩdryczka, M. Fungal biodiversity and their role in soil health. Front. Microbiol. 2018, 9, 1–9. [Google Scholar] [CrossRef]
- Mirmajlessi, S.M.; Destefanis, M.; Gottsberger, R.A.; Mänd, M.; Loit, E. PCR-based specific techniques used for detecting the most important pathogens on strawberry: A systematic review. Syst. Rev. 2015, 4, 9. [Google Scholar] [CrossRef] [PubMed]

| Targeted Organism | Number of Genome Assemblies | Median Total Length (Mb) | Median Protein Count | Median GC% |
|---|---|---|---|---|
| Verticillium dahliae | 11 | 33.2952 | 10393 | 55.6 |
| Verticillium alfalfae | 2 | 32.7521 | 10237 | 55.4 |
| Verticillium tricorpus | 2 | 35.5915 | nd | 57.4 |
| Verticillium nonalfalfae | 2 | 32.9671 | 9431 | 54.8 |
| Verticillium albo-atrum | 1 | 36.4685 | nd | 56.5 |
| Verticillium longisporum | 2 | 99.8546 | 20932 | 53.05 |
| Verticillium isaacii | 1 | 35.6909 | nd | 57.5 |
| Verticillium zaregamsianum | 1 | 37.1319 | nd | 57.5 |
| Verticillium klebahnii | 1 | 36.0824 | nd | 57.6 |
| Verticillium nubilum | 1 | 37.9116 | nd | 53.7 |
| Phytophthora infestans | 2 | 190.329 | 17797 | 36.9 |
| Phytophthora capsici | 7 | 56.0343 | nd | 49.9 |
| Phytophthora ramorum | 23 | 40.7668 | nd | 54 |
| Phytophthora nicotianae | 3 | 71.414 | 13910 | 50.2 |
| Phytophthora cactorum | 2 | 63.5331 | 24172 | 49.65 |
| Phytophthora rubi | 2 | 76.9186 | nd | 53.15 |
| Phytophthora fragariae | 2 | 76.4756 | nd | 53.2 |
| Phytophthora cinnamomi | 4 | 58.3834 | nd | 54 |
| Phytophthora parasitica | 9 | 54.2899 | 27003 | 49.6 |
| Phytophthora kernoviae | 11 | 38.1112 | 9990 | 50.3 |
| Phytophtora lateralis | 5 | 49.0253 | nd | 53.3 |
| Phytophthora palmivora | 1 | 107.773 | 24271 | 48.7 |
| Phytophthora sojae | 1 | 82.5976 | 26489 | 54.4 |
| Phytophthora litchii | 1 | 38.2009 | nd | 49.2 |
| Phytophthora colocasiae | 1 | 56.5926 | nd | nd |
| Phytophthora agathidicida | 2 | 37.2895 | nd | 52.6 |
| Phytophthora pluvialis | 2 | 53.178 | nd | 54.2 |
| Phytophthora multivora | 2 | 40.1961 | nd | 51.9 |
| Phytophthora pinifolia | 1 | 94.6173 | nd | 54.9 |
| Phytophthora cryptogea | 1 | 63.8393 | nd | 51.9 |
| Phytophthora cambivora | 1 | 230.616 | nd | 52.9 |
| Phytophthora plurivora | 1 | 40.4412 | nd | 51.7 |
| Phytophthora megakarya | 1 | 101.505 | 34804 | 48.7 |
| Phytophthora x alni | 1 | 236 | nd | 51.3 |
| Phytophthora pisi | 1 | 58.8567 | nd | 54.6 |
| Botrytis cinerea | 4 | 41.8726 | 13703 | 42.26 |
| Colletotrichum acutatum | 2 | 48.5246 | nd | 50.8 |
| Targeted Organism (Number of Strains Analyzed) | Assay | Marker | Primers Sequences 5′-3′ | Primers Authors | Primers Used in |
|---|---|---|---|---|---|
| V. albo-atrum (5) V. tricorpus (7) | multi-plex PCR | ITS1 | CCGGTCCATCAGTCTCTCTG CTGTTGCCGCTTCACTCG | [79] | [79] |
| V. longisporum (42) | EF2 | AAGTGGAGCCCCGTATCTTGAAT CAACTGGCAACAGGGCTTGAAT | |||
| V. isaacii (14) | CGATGTCGCGATGACCTCG CGGCAGCCTCCTAAACATGG | ||||
| V. klebahnii (7) | ACATCCTGAGGCTGCTTGAGA CGGCAGCCTCCTAAACATGG | ||||
| V. zaregam- sianum (10) | GPD3 | GGTTTCCTCCCCTCACACG CCACCCTTGATGTGGGCGGA | |||
| V. longisporum (42) | CCCCGGCCTTGGTCTGAT TGCCGGCATCGACCTTGG | ||||
| V. alfalfae (7) | TCATGCCCCCTTTGTTCATCGAT TGCCGGCATCGACCTTGG | ||||
| V. albo-atrum (5) | ACT | GGCCTCGATAGCATCGCC CTGGATGGAGACGTAGAAGGC | |||
| V. tricorpus (5) | CGTGCTGTCTTCCGTAAGTTTG CTGGATGGAGACGTAGAAGGC | ||||
| V. nonalfalfae (9) | TS5 | CCTCGAAAAATCCACCAGCTCTA GTGGTTGAGATCCTCACGCTTC | |||
| V. nubilum (4) | GGTCCCCCTCGTTCATGCAATC GTGGTTGAGATCCTCACGCTTC | ||||
| V. dahliae (10) V. longisporum (10) | PCR | ITS1 | GGA AGTAAAAGTCGTAACAAGG TCCTCCGCTTATTGATATGC | [91] | [19] |
| COX36 | TGATTTAGAGATST AATATCAGAAG CCGTGGAAACCTGTSCCAAAATA | [19] | |||
| NAD1 7 | ATGGCSAGTATGCAAAGAAGA GCATGTTC TGTCATAAASCCACTAAC | [92] | |||
| Verticillium spp. (7) | qPCR | ITS1 | CTTGGTCATTTAGAGGAAGTAA AAAGTTTTAATGGTTCGCTAAGA | [80] | [80] |
| V. tricorpus (4) | qPCR | ITS1 | CCGGTGTTGGGGATCTACT GTAGGGGGTTTAGAGGCTG | [91] | [83] |
| V. dahliae (9) + V. longisporum | β-tubulin | GGCCAGTGCGTAAGTTATTCT ATCTGGTTACCCTGTTCATCC | [84] | ||
| V. longisporum (11) | β-tubulin | GCAAAACCCTACCGGGTTATG AGATATCCATCGGACTGTTCGTA | |||
| V. dahliae (1) + V. longisporum (1) | qPCR | ITS1 | CAGCGAAACGCGATATGTAG GGCTTGTAGGGGGTTTAGA | [93] | [93] |
| V. dahliae (44) | qPCR | IGS8 | CGTTTCCCGTTACTCTTCT GGATTTCGGCCCAGAAACT | [87] | [87] |
| V. tricorpus (13) | endochitinase | TAGTAGAATACTAGATARCTAG AGCCTAGGTCTTTATAGCTAG | |||
| V. dahliae | CTCGGAGGTGCCATGTACTG ACTGCCTGGCCCAGGTTC | ||||
| V. dahliae | β-tubulin | GCGACCTTAACCACCTCGTT CGCGGCTGGTCAGAGGA | |||
| G3PD9 | CACGGCGTCTTCAAGGGT CAGTGGACTCGACGACGTAC | ||||
| VTP110 | GCGGTGGCTGGTTCCTATCAAC CAACGACTTCGCCATCTGGAAG | ||||
| V. albo-atrum group 1 (isolation from soil) | qPCR | actin | GCCCTCTTCCAGCCCTCCGTTCTC TCGGCGTGGTTTTGTGGTGAG | [87] | [94] |
| V. albo-atrum group 2 (isolation from soil) | qPCR | IGS8 | CGTGTTTAGTGTATTTCACCCTTG TCGCAGAGTAGTACGATTTCTC | [94] | |
| V. longisporum (isolation from soil) | CGAGGAGTGAAAAGAAAACGGTTA CGCGCCGAGGCTAGTCAC | ||||
| V. dahliae (5) | qPCR | not explained in the study | TCCTAGGCAGGCGAGCAG TAGGGCTGTCTGTCGGTGA | [90] | [90] |
| V. albo-atrum (4) | TTTCACGACCGATGAAAGCG CACATCGGCGAGGATCTGTC | ||||
| V. tricopus (4) | CACCCTCGGGCACACCAATA TCCGTGGAGGTTGAGCGCTAT | ||||
| V. longisporum (4) | CGAGGAGTGAAAAGAAAACGGTTA CGCGCCGAGGCTAGTCAC |
| Targeted Organism (No. of Strains Analyzed) | Assay | Marker | Primers Sequences 5′-3′ | Primer Authors | Primers Used in |
|---|---|---|---|---|---|
| Phytophthora spp. (15 in [101]; 14 in [102]) | PCR | ITS1 | GGAAGTAAAAGTCGTAACAAGG TCCTCCGCTTATTGATATGC | [91] | [101,102] |
| Phytophthora spp. (51) | PCR | COX12 | GCGTGGACCTGGAATGACTA AGGTTGTATTAAAGTTTCGATCG | [114] | [114] |
| COX23 | AAAAGAGAAGGTGTTTTTTATGGA GCAAAAGCACTAAAAATTAAATATAA | ||||
| P. ramorum | nested PCR | Spacer sequences between the COX 2 and COX1 gene | GTATTTAAAATCATAGGTGTAATTTG TGGTTTTTTTAATTTATATTATCAATG | ||
| P. nemorosa | AATAAAATTAATTTTAATATATAATTAG TATGTTTAATATCTGTAAATAATAG | ||||
| P. pseudo- syringae | CAGTTTCATTAGAAGATTATTTAC AAAATTGTTTGATTTTATTAAGTATC | ||||
| Phytophthora spp. (82) | PCR | 60S ribosomal protein L10 | GCTAAGTGTTACCGTTTCCAG ACTTCTTGGAGCCCAGCAC | [106] | [106] |
| β-tubulin | GCCAAGTTCTGGGARGTSAT GCCAAGTTCTGGGARGTSAT | ||||
| Enolase | CTTTGACTCGCGTGGCAAC CCTCCTCAATACGMAGAAGC | ||||
| Heat shock protein 90 | GCTGGACACGGACAAGAACC CGTGTCGTACAGCAGCCAGA | ||||
| tigA gene fusion | TTCGTGGGCGGYAACTGG TCGTGGGCGGYAAYTGGAA GCCTACATCACGGAGCARA TCGCYATCAACGGMTTCGG CCGAAKCCGTTGATRGCGA GCCCCACTCRTTGTCRTACCAC | ||||
| EF 4 | GGTCACCTGATCTACAAGTGC CCTTCTTGTTCACCGACTTG | ||||
| P. infestans (1) | qPCR | GC-rich nuclear satellite DNA with unknown function | GCCAT CAAGACGTGCGAGA GCAGGGATTCGGGCATA | [108] | [108] |
| P. citricola (1) | ITS1 | TCAACCCTTTTAGTTGGGGGTC TTTAAAACAAAAAGCTACTAGCCCAGAC | |||
| Phytophthora spp. (71) | qPCR | ITS1 | TGCGGAAAGGATCATTACCACACC GCGAGCCTAGACATCCACTG | [109] | [109] |
| P. colocasiae (49) | qPCR | YPT15 | GGTGTGGACTTTGTGAGTTTCAG AAGGGAGTTGGCACAACCATT | [111] | [111] |
| TRP16 | AGCGCCTTAACGCTCCCT GAGCCCTTGAACCACTTGGG | ||||
| GPA17 | TTGGTGGCGTGTAGTCTGTG AGCTTCCGGTTGATGGTAGC | ||||
| Phytophthora spp. (15) | qPCR | YPT14 | ATGAACCCCGAATAGTRCGTGC TGTTSACGTTCTCRCAGGCG | [115] | [115] |
| TRP16 | GAGGAGATCGCGGCGCAGCG GCGCACATRCCGAGVTTGTG | ||||
| GPA17 | GGACTCTGTGCGTCCCAGATG ATAATTGGTGTGCAGTGCCGC | ||||
| P. nicotianae (7) | qPCR | ITS1 | CCTATCAAAAAAAAGGCGAACG TACACGGAAGGAAGAAAGTCAAG | [112] | [112] |
| P. cactorum (7) | YPT15 | CATGGCATTATCGTGGTGTA GCTCTTTTCCGTCGGC |
| Targeted species (No. of Strains Analyzed) | Assay | Marker | Primers Sequences 5′-3′ | Primer Authors | Primers Used in |
|---|---|---|---|---|---|
| Botrytis spp. (1) | PCR | ITS1 | GGAAGTAAAAGTCGTAACAAGG TCCTCCGCTTATTGATATGC | [91] | [125] |
| B. cinerea (13) | PCR | ITS1 | ACCCGCACCTAATTCGTCAAC GGGTCTTCGATACGGGAGAA | [123] | [123] |
| B. cinerea (29) | PCR | RAPD 2 marker | CAGGAAACACTTTTGGGGATA GAGGGACAAGAAAATCGACTAA | [124] | [124] |
| B. fabae (8) | NEP13 | TCACGGTTTCTTGTCCATCC TCGGGCGTTGTACTCTTCAT | |||
| B. fabiopsis (8) | RAPD2 marker | TCCTTTCTATCCTCGCTGCC CTGGTGGTTTGTAAAGCTGC | |||
| Botrytis spp. (52) | PCR | RPB24 | GATGATCGTGATCATTTCGG CCCATAGCTTGCTTACCCAT | [135] | [135] |
| G3PDH5 | ATTGACATCGTCGCTGTCAACGA ACCCCACTCGTTGTCGTACCA | ||||
| HSP606 | CAACAATTGAGATTTGCCCACAAG GATGGATCCAGTGGTACCGAGCAT | ||||
| B. cinerea (39 in [49]; 273 in [35]) | PCR | microsatellite marker | ACCCGCACCTAATTCGTCAAC GGGTCTTCGATACGGGAGAA | [49] | [35] |
| B. cinerea (117 in [136]) | PCR | microsatellite marker | AAGCCCTTCGATGTCTTGGA ACGGATTCCGAACTAAGTAA | [136] | [35] |
| B. cinerea (75 in [137]) | PCR | microsatellite marker | AGGGAGGGTATGAGTGTGTA TTGAGGAGGTGGAAGTTGTA | [137] | [35] |
| microsatellite marker | CATACACGTATTTCTTCCAA TTTACGAGTGTTTTTGTTAG | ||||
| microsatellite marker | GGATGAATCAGTTGTTTGTG CACCTAGGTATTTCCTGGTA | ||||
| microsatellite marker | CATCTTCTGGGAACGCACAT ATCCACCCCCAAACGATTGT | ||||
| microsatellite marker | CGTTTTCCAGCATTTCAAGT CATCTCATATTCGTTCCTCA | ||||
| microsatellite marker | ACTAGATTCGAGATTCAGTT AAGGTGGTATGAGCGGTTTA | ||||
| microsatellite marker | CCAGTTTCGAGGAGGTCCAC GCCTTAGCGGATGTGAGGTA | ||||
| microsatellite marker | CTCGTCATAACCACGCAGAT GCAAGGTCTCGATGTCGATC | ||||
| microsatellite marker | TCCTCTTCCCTCCCATCAAC GGATCTGCGTGGTTATGACG | ||||
| B. cinerea (1) | qPCR | β-tubulin | CCGTCATGTCCGGTGTTACCAC CGACCGTTACGGAAATCGGAAG | [130] | [130] |
| actin | TGGAGATGAAGCGCAATCCAA AAGCGTAAAGGGAGAGGACGG | ||||
| B. cinerea (1) | qPCR | cutinase A | AGCCTTATGTCCCTTCCCTTGCG GAAGAGAAATGGAAAATGGTGAG | [131] | [131] |
| B. cinerea (24) | qPCR | β-tubulin | GTTACTTGACATGCTCTGCCATT CACGGCTACAGAAAGTTAGTTTCTACAA | [132] | [132] |
| IGS7 | FGCTGTAATTTCAATGTGCAGAATCC GGAGCAACAATTAATCGCATTTC | ||||
| SCAR8 marker | TTCGTGATTATCACCTGGGTTG GCTCCTAGAACGTACGACCACA | [123] | |||
| B. cinerea (11) | multi-plex qPCR | β-tubulin | GTCGTCCCATCGCCAAAGGT ACGGTGACAGCACGGAAAGA | [134] | [134] |
| SdhB9 | ACACCGACCCAGCACCAGA TTAGCAATAACCGCCCAAA | ||||
| BcOS110 | AGGTCACCCGCGTAGCAAGA TGCTTGATTTCACCCTTACA | ||||
| erg2711 | GCGTGGAGAACTCTAAATCGG AGTGTAAGGCTTGATGGTATGC |
| Targeted species (No. of Strains Analyzed) | Assay | Marker | Primers Sequences 5′-3′ | Primer Authors | Primers Used in |
|---|---|---|---|---|---|
| C. acutatum (16 in [146]) | PCR | ITS1 | GGAAGTAAAAGTCGTAACAAGG TCCTCCGCTTATTGATATGC | [91] | [146] |
| C. acutatum (16 in [146]) | PCR | LSU2 | ATCCTGAGGGAAACTTC AGATCTTGGTGGTAGTA | [155] | [146] |
| Colletotrichum spp. (29) | PCR | ITS1 | AACCCTTTGTGAACRTACCTA TTACTACGCAAAGGAGGCT | [156] | [156] |
| Colletotrichum spp. (100 in [151] | PCR | GPDH3 | TCCCATCAAGGTCGGCATCA ACCTTGCCGACAGCCTTGG | [157] | [151] |
| CHS-14 | GATGCCTGGAAGAAGATTGTCGT GTCTCGCCAGTAGCGGACTTGAC | ||||
| CAL 5 | GAATTCAAGGAGGCCTTCTC CTTCTGCATCATGAGCTGGAC | ||||
| C. acutatum (181) | PCR | Cytb 6 | GAAGAGGTATGTACTACGGTTCATATAG TAGCAGCTGGAGTTTGCATAG | [152] | [152] |
| C. acutatum (23 in [70]) | qPCR | ITS1 | CGGAGGAAACCAAACTCTATTTACA CCAGAACCAAGAGATCCGTTG | [91] | [70] |
| C. acutatum (6) | qPCR | ITS1 | GGATCATTACTGAGTTACCGC GCCCACGAGAGGCTTC | [153] | [153] |
| β-tubulin | CGTCTACTTCAACGAAGTTTGTTATCC GAGGCCTGGTTGGGTGAG | ||||
| C. acutatum (15) | qPCR | histone H3 | TCCAGCGTCTGGTAAGTTGAGAA AGAAGTGTTAGCCGATGCGATT | [154] | [154] |
© 2019 by the authors. Licensee MDPI, Basel, Switzerland. This article is an open access article distributed under the terms and conditions of the Creative Commons Attribution (CC BY) license (http://creativecommons.org/licenses/by/4.0/).
Share and Cite
Malarczyk, D.; Panek, J.; Frąc, M. Alternative Molecular-Based Diagnostic Methods of Plant Pathogenic Fungi Affecting Berry Crops—A Review. Molecules 2019, 24, 1200. https://doi.org/10.3390/molecules24071200
Malarczyk D, Panek J, Frąc M. Alternative Molecular-Based Diagnostic Methods of Plant Pathogenic Fungi Affecting Berry Crops—A Review. Molecules. 2019; 24(7):1200. https://doi.org/10.3390/molecules24071200
Chicago/Turabian StyleMalarczyk, Dominika, Jacek Panek, and Magdalena Frąc. 2019. "Alternative Molecular-Based Diagnostic Methods of Plant Pathogenic Fungi Affecting Berry Crops—A Review" Molecules 24, no. 7: 1200. https://doi.org/10.3390/molecules24071200
APA StyleMalarczyk, D., Panek, J., & Frąc, M. (2019). Alternative Molecular-Based Diagnostic Methods of Plant Pathogenic Fungi Affecting Berry Crops—A Review. Molecules, 24(7), 1200. https://doi.org/10.3390/molecules24071200

